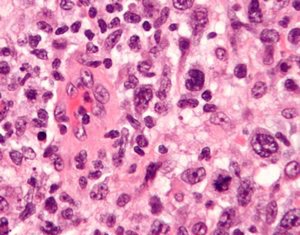

Sign up for FlowVella
Sign up with FacebookAlready have an account? Sign in now
By registering you are agreeing to our
Terms of Service
Loading Flow

Stage I(early disease)- The cancer is located in a single lymph, in one organ or area outside lymph node
The ALCL includes four stages
Stage II- Means that it's locally advanced. This means the cancer is found in two or more lymph node regions on the same side of the diaphragm.
Stage III- Its advanced disease as 2 or more nodes are found above and below diaphragm
Stage IV- Widespread disease meaning that the lymphoma has spread beyond the lymph nodes and spread to one or more organs